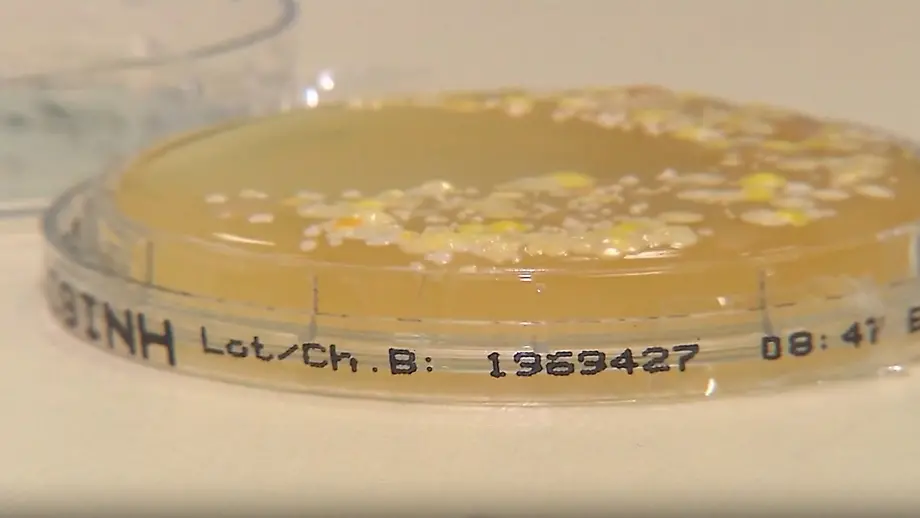
Video poster

Video
Jeder Vierte hat Klinik-AngstSo gefährlich sind Krankenhauskeime wirklich
03.12.2025, 10:07 UhrEtwa 20 Millionen Bundesbürger fürchten sich vor Krankenhausbehandlungen, belegt eine aktuelle Erhebung. Multiresistente Erreger infizieren jährlich 600.000 Menschen in Deutschland. ntv erklärt, welche Patienten besonders gefährdet sind.
Topvideos